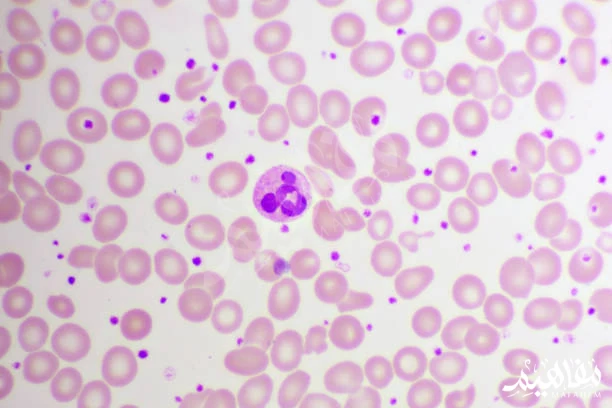
thrombocytopenia thrombocytopenia

أهم أسباب وأعراض نقص الصفائح الدموية وطرق العلاج والوقاية منه

جدول المحتويات
- أسباب نقص الصفائح الدًموية
- أعراض ظاهرة نقص الصفائح الدموية
- كيفية العلاج من ظاهرة نقص الصفائح الدًموية؟
- كيفية تشخيص الإصابة بنقص الصفائح الدًموية؟
- نصائح يجب إتباعها عند نقص الصفائح بالدم
- متى تكون نسبة عدد الصفائح الدًموية خطير؟
- ماذا يحدث عند نقص الصفائح الدًموية؟
- ما هي نسبة الصفائح الدموية الطبيعية؟
- انخفاض عدد الصفائح الدموية والسرطان
- ما هي الأطعمة التي تزيد من الصفائح الدموية؟
أسباب نقص الصفائح الدًموية
- هناك العديد من الأسباب التي تساهم في حدوث ظاهرة نقص الصفائح الدًموية من جسم الإنسان، ولأنه نوع من أنواع الأمراض العارضة، يتساءل العديد من الأشخاص عن الأسباب التي ساهمت في حدوثها، والتي نفصلها لكم كالتالي:
- حدوث خلل في الجدار المناعي الخاص بك، حيث أن الفيروسات والبكتريا التي يتعرض لها الجسم بشكل مباشر تقضي بشكل كبير على الصفائح الدموية في جسدك، مما يجعلك أيضا عرضي للإصابة بالفيروسات الضارة.
- أن يكون عامل نقص الصفائح الدموية متوارث من الوالدين، وهو الاحتمال الأكثر شيوعاً ما بين الاحتمالات الأخرى،حيث أن معظم المصابين بظاهرة نقص الصفائح الدُموية متوارث لديهم من الوالدين.
- قد يكون أيضا ناتجا عن الإصابة بنوع من أنواع السرطانات التي تساهم في قتل الصفائح الدموية في جسم الإنسان.
- إدمانالمكشروباتالكحولية أو التدخين بشراهة، مما يؤثر على التكوين الداخلي للجسم.
- حدوث الحمل، حيث أن تكوين الجنين وبنائه يعمل على فقدان الكثير من العناصر الهامة بجسم الأم والتي تعتر الصفائح الدموية من أهمها.
- الخلط في استخدام بعض الأدوية دون العلم بالآثار الجانبية التي قد تترتب عليها، فهناك بعض العقاقير الطبية التي قد تساهم بشكل غير مباشر في نقص الصفائح الدموية من الجسم، لذا ينصح دائما باستشارة الطبيب قبل أخذ أي نوع من أنواع الأدوية الطبية دون العلم بآثارها الجانبية.
أعراض ظاهرة نقص الصفائح الدموية
هناك العديد من الأعراض التي تنتج عن نقص الصفائح الدًموية في الجسم، والتي تحدث في حالة حدوث نقص حاد في الصفائح الدموية المتواجدة داخل جسم الإنسان، وعلى ذلك يطرأ العديد من الأعراض التي تعد بمثابة إنذار لفقد الصفائح الدموية، وتلك الأعراض نبينها لكم بالتفصيل كالتالي:
- حدوث نوع من أنواع التقرح الدموي الذي ينتج عن نقص الصفائح الدموية، فيمكن لهذا التقرح أن يحدث في اللثة، كما يمكن أن يحدث نزيف دموي في السائل الإخراجي عند السيدات.
- نشأة سلسلة متوالية من النقاط ذات اللون الأحمر تنتشر بشدة على مشط القدم والفخذين، قد تتفاوت في الحجم والكمية.
- ظهور العديد من التكدمات الناتجة عن الإصابة بنزيف دموي أسفل طبقات جلد البشرة، حيث أَنها تتكون في أماكن متفرقة من جسدك تحمل لون أقرب إلى اللون الأزرق القاتم.
- تخثر الدم بشكل كبير في حالة حدوث أي نوع من أنواع الإصابات التي تسبب جراحة، وقد تؤدي إلى الوفاة من إصابات ليست خطيرة للغاية، ألا إن نقص الصفائح الدموية أدى إلى فقدان جزء كبير من الدم الذي يؤدي إلى الوفاة.
- نزول دماء الدورة الشهرية بشكل نزيف ذو لون قاتم ولمدة طويلة قد تتجاوز سبع أيام.
- وجود نقص في العديد من العناصر والمعادن والفيتامينات التي يجب أن تتوافر داخل الجسم مثل معدن الحديد.

كيفية العلاج من ظاهرة نقص الصفائح الدًموية؟
هناك العديد من الأنواع التي تساهم في علاج ظاهرة نقص الصفائح الدموية، والتي يمكنك اختيار واحدة منهم للمساهمة في علاج نقص الدم عندك بالطريقة التي تناسبك دون ضرر، فقط إتباع واحدة من أنواع وسائل العلاج المبينة لكم كالتالي؛
العلاج بالوصفات الطبية
- حيث أنها واحدة من أنواع وسائل العلاج التي تساهم بشكل فعال ومباشر في علاج نقص الصفائح الدموية، فقط قم بزيارة طبيب واتبع النظام العلاجي الذي سوف يخصصه لك بأخذ العقاقير والحبوب التي سوف ينصحك بها.
- وتتمثل في جرعات من دواء ديكساميثازون أو بريدنيزون التي تساعد على رفع عدد الصفائح الدموية في الدم.
- أدوية تعزيز وتثبيط المناعة مثل الآزويثوبرين والسيكلوسبورين أو الجلولوبين المناعي والتي تعزز عمل جهاز المناعة.
- كما يمكن على الاعتماد على العلاج البيولوجي في مهاجمة الخلايا المسؤولة عن نقص الصفائح.
اتباع نظام غذائي صحي
- حيث أن الغذاء الصحي هو أولى العناصر التي تساهم بشكل فعال في العلاج من العديد الأشياء وليس فقط لعلاج نقص صفائح الدم، وهو الحل الأمثل في وجهة نظر الأطباء، حيث أن طبق واحداً من الخضروات يومياً يعوض الجسم بالنسبة الكاملة من الصفائح الدموية.
- تناول الفواكه بمقدار كافي يساهم بشكل فعال في التعزيز من عمل الصفائح الدموية في الجسم، فقط ابتعد عن الأطعمة الجاهزة والمشروبات المعلبة.
- الحرص على تناول مقدار كافي من الفواكه والأطعمة التي تحتوي على نسبة السكر مثل المانجو والموز والفراولة.
كيفية تشخيص الإصابة بنقص الصفائح الدًموية؟
يمكن تشخيص حالة نقص الصفائح الدًموية من قبل الطبيب بالعديد من الفحوصات الضرورية التي يجب أن تتم للتأكد من وجود نقص في الصفائح الدموية للمريض، وهي تتكون من:
- الكشف على جسدك، حيث يقوم الطبيب بالبحث عن العديد من الدلالات الجسدية التي قد تكون ناتجة عن إحدى أعراض نقص الصفائح الدموية، مثل التكدمات أو النقط الحمراء، أو وجود نوع من أنواع الانتفاخ في الجهة التي يتواجد بها جهاز الطحال.
- القيام بتحليل الدم، للتعرف إلى نسبة صفائح الدم المتواجد بداخل جسدك، والتي يجب أن تكون ما بين 15000-50000 صفيحة دموية لكل ملليلتر.
- كما يقوم هذا التحليل بالتعرف على نسبة سيولة الدم في جسدك، هل هي بشكل طبيعي أم مفرط عن الدرجة الطبيعة السيولة.
نصائح يجب إتباعها عند نقص الصفائح بالدم
من أهم النصائح التي يوصي مرضى نقص الصفائح باتباعها ما يلي:
- يجب على مريض نقص الصفائح الدموية أن يتبع العديد من الأشياء والإرشادات التي من شأنها أن تحافظ على نسبة الصفائح الدموية المتواجدة داخل جسدك، دون الإصابة بأي نوع من أنواع الأمراض.
- الابتعاد عن أنواع الممارسات الرياضية التي تتطلب مجهوداً بدنياً كبير قد يساهم في حدوث العديد من التكدمات داخل الجسم.
- تناول الخضروات والفاكهة بشكل دائم وبمقدار يكفي الجسم من الفيتامينات والمعادن يوميا، حيث أن الفواكه تعد مصدراً رئيسياً لإمداد الجسم بالصفائح الدموية التي يحتاجها يوميا.
- الابتعاد عن أصناف الطعام التي لا تحتوي على أي نسبة من السكر.
- ينصح بعدم تناول المشروبات والأطعمة المعلبة التي تحتوي على نسبة كبيرة من مواد حافظة.
- ابتعد عن أنواع الخضروات أو الفواكه الحمضية مثل البرتقال والليمون.
- محاولة الاكتفاء عن تناول بعض الأدوية التي تحتوي على آثار جانبية تساهم في نقص الصفائح الدموية من الجسم، والتأكد من الطبيب من نوع الأدوية التي يتم استخدامها.
- الابتعاد عن أي عادات من شأنها أن تضر بالتأثير السلبي على الصفائح الدموية مثل شرب السجائر والكحوليات والإدمان، فإنه يعمل بشكل كامل على تدمير الصفائح الدموية المتواجدة في جسدك.
- الابتعاد قدر الإمكان عن الوسائل التي قد تتسبب في حدوث إصابة جراحية كبير لك.
- احرص على تناول الأشياء التي تساهم في تعزيز جهاز المناعة الخاص بك.
- الكشف المبكر والسريع في حالة التعرض لإحدى أعراض نقص الصفائح الدموية.
متى تكون نسبة عدد الصفائح الدًموية خطير؟
- يمكن أن يحدث نزيف داخلي خطير عندما يقل عدد الصفائح الدموية عن 10 جم / لتر أو 10000 صفيحة لكل ميكروليتر (ميكرولتر). على الرغم من أن قلة الصفيحات الشديدة حالة نادرة، إلا أنها يمكن أن تسبب نزيفًا في الدماغ، والذي يمكن أن يكون قاتلًا.

ماذا يحدث عند نقص الصفائح الدًموية؟
- بشكل عام، تتميز "قلة الصفيحات الدموية بانخفاض عدد الصفائح الدموية (الصفيحات) في الدم، مما يزيد من خطر حدوث نزيف.
- يتجلى نقص الصفائح الدموية بشكل مختلف اعتمادًا على شدة قلة الصفيحات: كدمات أو "كدمات" عند أدنى ضربة، نزيف اللثة عند تنظيف الأسنان ، فترات غزيرة وطويلة بشكل غير طبيعي.
- دم في البراز أو حتى نزيف دماغي أو سحائي.
ما هي نسبة الصفائح الدموية الطبيعية؟
- يختلف عدد الصفائح الدموية الطبيعي، (معدل الصفائح الدموية) بشكل عام لدى الشخص البالغ من 150000 إلى 400000 صفيحة لكل ميكروليتر (ميكرولتر) من الدم، أي 150 إلى 400 جم / لتر.
- وجود أكثر من 400 جم / لتر (أو 400 × 10 9 / لتر) هو حالة تسمى "كثرة الصفيحات" (ارتفاع مستوى الصفائح الدموية).
- وجود أقل من 150 جم / لتر (150 × 10 9 / لتر) يُعرف باسم "قلة الصفيحات" (انخفاض عدد الصفائح الدموية في الدم).
انخفاض عدد الصفائح الدموية والسرطان
- يمكن لبعض أنواع السرطان مثل اللوكيميا أو سرطان الجهاز الليمفاوي (سرطان الغدد الليمفاوية الخبيثة أو الساركوما اللمفاوية) خفض عدد الصفائح الدموية.
- يمكن للخلايا غير الطبيعية من هذه السرطانات أن تزاحم الخلايا السليمة في نخاع العظام، حيث تتكون الصفائح الدموية.
- تشمل الأسباب الأقل شيوعًا لانخفاض عدد الصفائح الدموية السرطان الذي ينتشر في العظام أو سرطان الطحال.
ما هي الأطعمة التي تزيد من الصفائح الدموية؟
لا توجد دراسة جادة أثبتت التأثير المفيد الحقيقي للغذاء أو المكملات الغذائية أو الفيتامينات على انخفاض عدد الصفائح الدموية، ولكن يوصي بالآتي:
- الاستثناء الوحيد هو قلة الصفيحات في فقر الدم في بيرمر (مرض بيرمر وسوء الامتصاص ونقص فيتامين ب 12) حيث يتم وصف فيتامين ب 12.
- يدعي البعض أنهم يأكلون الفاصوليا الخضراء وبذور اليقطين والحمضيات والسبانخ، إلخ.
- يمكن لنمط الحياة الصحي والنظافة المناسبة والقواعد الغذائية فقط تجنب المضاعفات أو تفاقم قلة الصفيحات:
- وقف أو تقليل الأنشطة التي يمكن أن تسبب الجروح والصدمات؛
- اعتدال في استهلاك الكحول أو حتى أوقفه.
- تجنب تناول الأدوية مثل الأسبرين والآيبوبروفين.
للإستفادة من هذا المقال انسخ الرابط
https://mafahem.com/sl_3818











